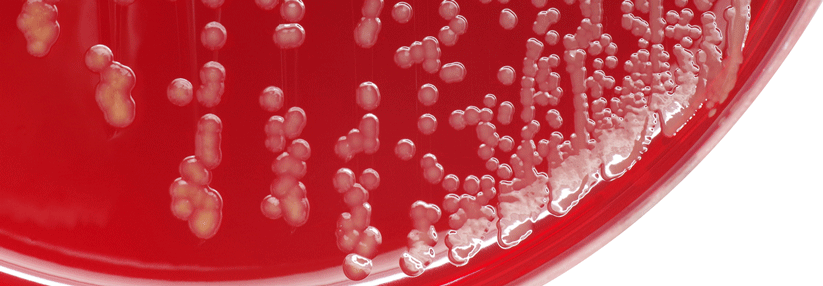

MRSA-Alarm bei Penicillinallergie
 Die Rate von Infektionen mit multiresistenten Bakterien ist bei Penicillinallergie deutlich erhöht.
© iStock/SrdjanPav
Die Rate von Infektionen mit multiresistenten Bakterien ist bei Penicillinallergie deutlich erhöht.
© iStock/SrdjanPav
Die Diagnose Penicillinallergie wirkt sich in besonderer Weise auf spätere antibiotische Behandlungen der Patienten aus. In deren Folge müssen Betroffene mit einem deutlich erhöhten Risiko für Infektionen mit methicillinrestistenten Staphylococcus-aureus(MRSA)-Stämmen sowie Clostridium difficile leben.
Zu diesem Ergebnis kommen Prof. Dr. Kimberly G. Blumenthal, Department of Medicine des Massachusetts General Hospital in Bosten und Kollegen. In einer populationsbasierten Kohortenstudie verglichen sie Daten von 64 141 hausärztlich versorgten Patienten mit diagnostizierter Penicillinallergie (ohne MRSA- oder C.-difficile-Infektion) mit mehr als 237 000 Patienten ohne Allergiediagnose.
In…
Bitte geben Sie Ihren Benutzernamen und Ihr Passwort ein, um sich an der Website anzumelden.